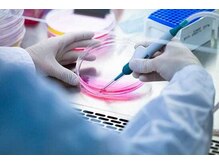
「ヒト幹細胞培養液」とは？

- こだわり1
- こだわり2
「髪のボリュームが気になってきた」「髪に透けて見える地肌が気になる」そんな悩みへCielの強髪プログラム
最近話題の【ヒト幹細胞培養液】で、ターンオーバーの周期を短くし、細胞活性を促進。髪の悩みの根本的改善はCielの強髪プログラムで!気になる詳細はこちら★
STEP1
STEP1「ヒト幹細胞培養液」とは?
ヒト幹細胞培養液にはコラーゲンやヒアルロン酸などの様々なタンパク質が含まれています。細胞を活性化させる機能があることから、エイジングケアに効果的であるとして今注目を集めています!
 STEP2
STEP2Cielの【強髪プログラム】とは?
CielではJSARM公認の国産ヒト幹細胞培養液を使用しています。頭皮にダイレクトに栄養を与えることで、ターンオーバーのサイクルを早めて頭皮をより健康な状態に変えていきます★頭皮と髪のお悩みがある人に、全力でお勧めします!
 STEP3
STEP3どんな人にオススメ?
ボリューム、抜毛、細毛、旋毛の分け目が気になる方。お肌のエイジングケアはばっちりだけど、頭皮と髪のエイジングケアは何もやっていない…。そんな方に、是非Cielの強髪プログラムを体験していただきたいです!
 STEP4
STEP4どのメニューを選べばいい?
ヒト幹細胞培養液は、濃度15%と100%をご用意しております。一度試してみたい方は15%、すぐに効果を実感したい方は100%をお勧めします。また、本気で改善したい方にお得な3回コースもご用意しております♪15%3回コース¥11880~100%3回コース¥29700~
 STEP5
STEP5何回受ければ効果を実感できる?
オススメのペースは2週間に1回。早い方は2~3回でも効果を実感していただけます★早く効果を出したい方は培養液100%の「HSC-NEO」を!※効果が出るまでには個人差があります。
 STEP6
STEP6ホームケア商品について
お忙しい方には、ご自宅で使用可能な簡易ケア美容液もご用意しております。約3cc頭皮に刷り込むだけで、頭皮の状態が改善していきます。詳しくはスタッフまでお声がけください♪
| 全 員 |
¥5,830 【ボリューム、分け目、抜毛に悩まない!】ヒト幹細胞培養液20&使用「強髪」
|
| 全 員 |
¥9,460 【NEW!】ボリューム改善!ヒト幹細胞培養液 強髪20%+シャンプーカット
|
| 全 員 |
¥11,290 【ボリューム、分け目、抜毛に!】ヒト幹細胞20%使用「強髪20」3回コース
|
| 全 員 |
¥23,760 【本気で髪を育むコース】ヒト幹細胞110使用「強髪NEO」3回コース~
|


